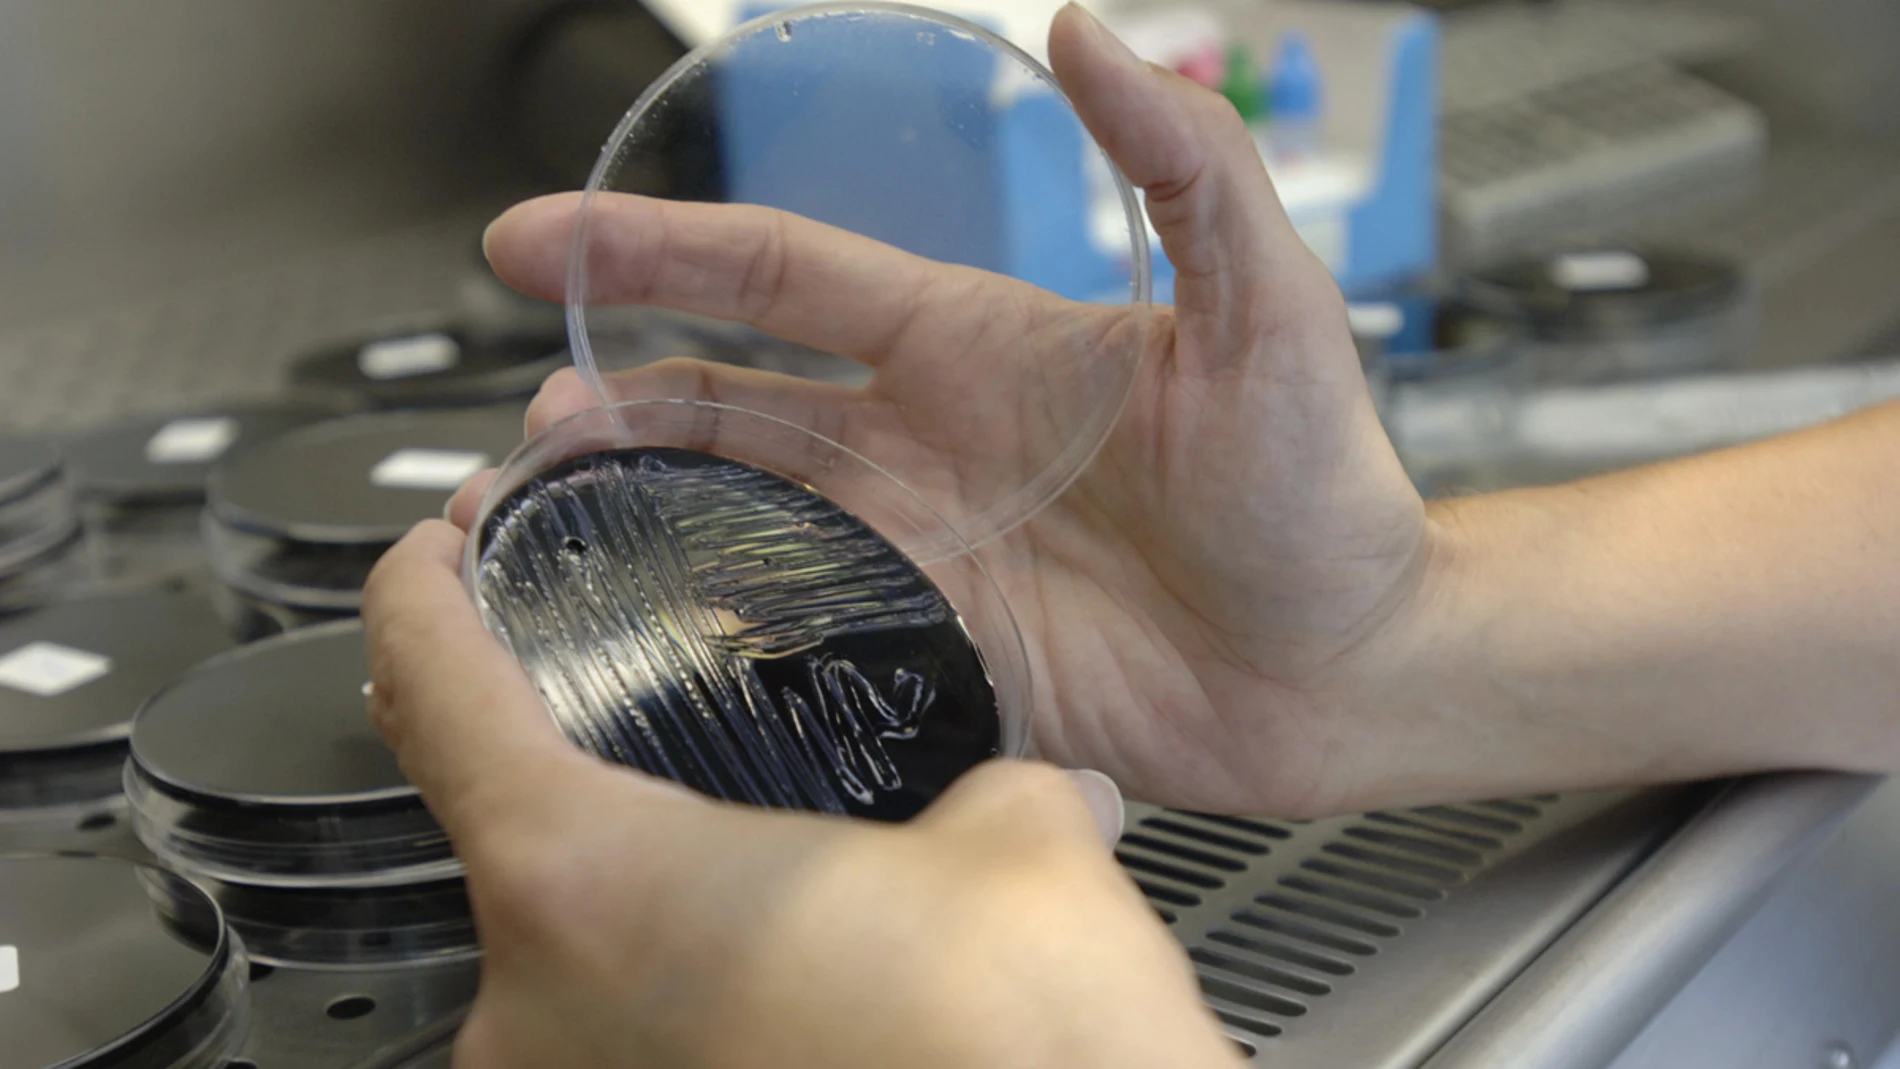
Muestra tomada en una torre de refrigeración Muestra tomada en una torre de refrigeración

TRES FALLECIDOS Y 236 AFECTADOS
La Fiscalía de Ciudad Real abre diligencias sobre el brote de legionela en Manzanares
En un comunicado, el fiscal jefe de Ciudad Real ha informado de que se ha abierto diligencias de investigación "para conocer de dónde proviene el foco de legionela y depurar responsabilidades". Por su parte, el Defensor del Paciente ha manifestado que apoya la decisión del fiscal "ya que son muchas las personas afectadas por una bacteria evitable".
Publicidad
La Fiscalía Provincial de Ciudad Real ha abierto diligencias de investigación sobre el brote de legionela de Manzanares (Ciudad Real), según ha asegurado la Asociación El Defensor del Paciente.
Así se lo ha comunicado el fiscal jefe de Ciudad Real, Luis Huete, a la presidenta de El Defensor del Paciente, Carmen Flores, en un escrito remitido el 23 de diciembre, en respuesta a la petición que le formuló la asociación el 18 de diciembre de que abriera una investigación de oficio "para conocer de dónde proviene el foco de legionela y depurar responsabilidades".
En el escrito Huete le comunica el acuse de recibo de su solicitud y le participa "que han sido incoadas diligencias de investigación preprocesales gubernativas, al amparo de lo establecido en el artículo 5 del Estatuto Orgánico del Ministerio Fiscal y al artículo 773.2 de la Ley de Enjuiciamiento Criminal".
En un comunicado, el Defensor del Paciente se ha congratulado "de la decisión del fiscal de la apertura de diligencias, ya que son muchas las personas afectadas por una bacteria evitable y de la que se deben responsabilizar a los anteriores y nuevos mandatarios de Castilla-La Mancha".
Según la asociación, "la pulcritud en la limpieza y revisión es la manera de evitar muertes y afectados, entendemos que los recortes de la señora Cospedal ha dado como fruto una sanidad que no cuenta con el suficiente personal para dichas revisiones".
Para El Defensor del Paciente "es imperativo realizar diagnósticos a los puntos que puedan ser conflictivos con la asiduidad necesaria para evitar estas situaciones, como decimos evitables y por tanto no asumibles".
El brote de legionela se detectó el pasado 11 de diciembre y ha afectado a 236 personas, de las cuales tres han fallecido.
Publicidad








